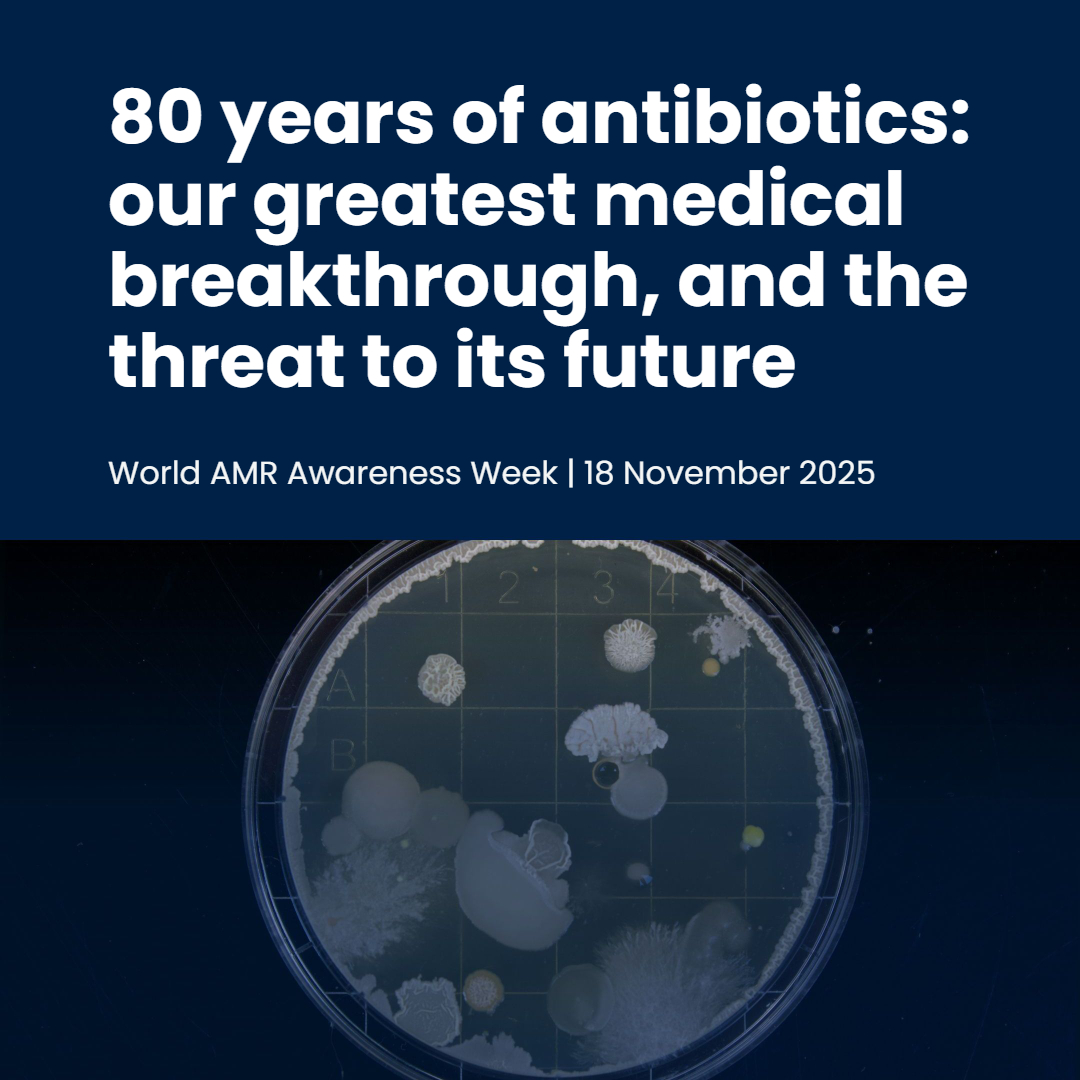
IneosOxford's tweet image. 💙It’s #WorldAMRAwarenessWeek!  

🧫80 years ago, penicillin changed modern medicine - but how does it work? And how do bacteria resist it? 

👉Read more to find out, and learn how the IOI protects our life-saving antibiotics: ineosoxford.shorthandstories.com/80-years-of-an…

#WAAW…

The Trinity Challenge
@TrinityChall
The Trinity Challenge is a charity supporting the creation of data-driven solutions to protect against global health threats. Founder: @UKAMREnvoy
Potrebbero piacerti
We are excited to be presenting at the AMR Beyond webinar series hosted by Young @WFPHA_FMASP on Sunday 23 November. Join us to explore #TTCYouth #AMR campaigns. Register using the QR code.

Thank you to everyone who shared their stories and helped bring our #ThankYouAntibiotics campaign to life - a powerful moment that reminds us how important #antibiotics are. Couldn’t make it to the Piccadilly Circus yesterday? Watch it here 👇
AMR affects everyone, from global health systems to local communities. Resistant bacteria make infections harder to treat. 'We all have a role to play. Staying up to date with vaccines, taking antibiotics only when prescribed and more are actions that can help us. @CAMO_Net1
The Trinity Challenge funds global innovators tackling the #AntibioticEmergency. From community-based transformation projects to youth-led awareness campaigns, we’re supporting the next generation of solutions to #AMR worldwide. Find out more - youtu.be/2NBPbp6uQIk #WAAW2025

💙It’s #WorldAMRAwarenessWeek! 🧫80 years ago, penicillin changed modern medicine - but how does it work? And how do bacteria resist it? 👉Read more to find out, and learn how the IOI protects our life-saving antibiotics: ineosoxford.shorthandstories.com/80-years-of-an… #WAAW…
Soap, Schools and Superbugs - for #WAAW2025, we’re celebrating young changemakers tackling #AMR through creativity, education and action. From Kazakhstan to Uganda to Nepal, they are proving that hygiene saves lives. Read our feature with @wateraid - washmatters.wateraid.org/blog/soap-scho…

What a response! We received 182 applications from 34 countries for the #TrinityChallenge Youth Competition on Educating for Behaviour Change. It is so inspiring to read your innovative ideas for raising awareness to tackle the #AntibioticEmergency. Watch this space for updates!
Youth Winner Dr Salman Khan from @reactgroup recently spoke at the @FAO Sustainable Livestock Conference in Rome about the #Biosecurity project 'From Campus to Farm'. Here he is explaining the campaign and its impact in Kerala, India, both now and in the future.
We recently attended @FAO Sustainable Livestock Conference in Rome where two of our Youth Winners spoke about their #Biosecurity campaigns. Here is Edna Wanjiru from @afri_isaaa speaking about G.O.A.T and its implementation in Kenya.
To mark #GlobalHandwashingDay we are spotlighting our first #TrinityChallenge Youth Competition Winners. Their #WASH in Schools campaigns created impact across the world! Watch for a reminder of our inspiring young leaders, working hard to mitigate #AMR: youtu.be/PQwPk4ouIPI
At the @WorldHealthSmt in Berlin, we convened global health leaders with partners from the Institute of Philanthropy to celebrate innovation and community-led impact. We committed to mitigating the #AntibioticEmergency through collaboration. Read more: thetrinitychallenge.org/news-and-stori…

So exciting to meet two of our youth winners, Salman Khan from @reactgroup and Ednah Wanjiru from @afri_isaaa, at the @FAO Global Conference on Sustainable @FAOLivestock Transformation. Their campaigns on #Biosecurity & #AnimalHealth were well received. More updates next week!
Antimicrobial resistance (AMR) is not just a human health problem. Domestic animals also receive antibiotics and the Fleming Initiative wants to ensure the prudent use of life-saving medicines amongst livestock.
We're pleased to be at FAO Sustainable @FAOLivestock Conference. @ThanawatTiensin of @FAO gave an opening speech on the need for better nutrition and better environment for a better life and the vital role of grassroots engagement with farmers and young people for real change.

DEADLINE EXTENSION! We want to give you more time to complete your applications for the #TrinityChallenge Youth Competition - apply before Tues 07 Oct at 17:00 BST for a chance to win up to £7,500 for your Behaviour Change Campaign! More info here: thetrinitychallenge.org/youth-voice/#b…

Looking for some inspiration for your campaign? Take a look at our #TrinityChallenge Youth video and see the real impact youth-led campaigns can have! We can't wait to see the innovative ideas brought forward for the Educating for Behaviour Change competition!…

youtube.com
YouTube
The Trinity Challenge - Youth Engagement on AMR
Have you submitted your #TrinityChallenge Youth Competition application? There is still time! We encourage you to share your ideas for campaigns on Educating for Behaviour Change in Antibiotic Resistance! thetrinitychallenge.org/youth-voice/#b…

Interested in applying to our #TrinityChallenge Youth Funding Competition to deliver impactful Antibiotic Resistance campaigns? Here are some top tips when creating your application... #BehaviourChange #Innovate #Funding #AMR #OneHealth thetrinitychallenge.org/youth-voice/#b…

We are proud to spotlight AMRoots, winners from the #TrinityChallenge on AMR. A tiny lab, led by Prof. Helen McIlleron , will help to tackle a #GlobalHealth crisis in South Africa’s rural eastern cape. Find out more: thetrinitychallenge.org/news-and-stori…

Reminder! We have our #TrinityChallenge Youth Competition Q&A webinar tomorrow 14:00 - 15:00 BST. If you want to know more about the process, eligibility criteria, topics or prize fund of up to £7,500 then sign up today - thetrinitychallenge.org/events/

United States Tendenze
- 1. Cheney 48.3K posts
- 2. First Take 42.8K posts
- 3. #ExpediaChat N/A
- 4. Nano Banana Pro 16.3K posts
- 5. Cam Newton 2,543 posts
- 6. Sedition 93K posts
- 7. Stephen A 37.7K posts
- 8. #AcousticPianoSnowGlobe 2,044 posts
- 9. Treason 58.6K posts
- 10. Trump and Vance 29.8K posts
- 11. #LoveDesignFinalEP 366K posts
- 12. SEDITIOUS BEHAVIOR 15.5K posts
- 13. FINAL DRAFT FINAL LOVE 401K posts
- 14. Bush 53.7K posts
- 15. #XboxPartnerPreview 2,273 posts
- 16. Eddie Hennessy N/A
- 17. Husqvarna 1,209 posts
- 18. Godzilla 20.9K posts
- 19. #WeekndTourLeaks 1,215 posts
- 20. Stuart Scott 2,416 posts
Potrebbero piacerti
-
 Dr. Madhuri Pydisetty Ⓥ🌱
Dr. Madhuri Pydisetty Ⓥ🌱
@madhuripydi -
 ReAct Africa Network (RAN)
ReAct Africa Network (RAN)
@ReActAfrica_RAN -
 CHAI
CHAI
@CHAI_health -
 Vital Voices
Vital Voices
@VitalVoices -
 Wellbeing Research Centre
Wellbeing Research Centre
@OxWellResearch -
 rani – Resilience Action Network International
rani – Resilience Action Network International
@rani_action -
 American Board of Emergency Medicine (ABEM)
American Board of Emergency Medicine (ABEM)
@ABEMCert -
 Richard Sved
Richard Sved
@richardsved -
 Solomon Thimothy
Solomon Thimothy
@sthimothy -
 SOLARIS Centre
SOLARIS Centre
@SOLARIS_science -
 Jake Dunning
Jake Dunning
@OutbreakJake -
 Mehak Dhande, MD (she/her)
Mehak Dhande, MD (she/her)
@MehakDhande -
 Yale Heart Failure
Yale Heart Failure
@YaleHF -
 College of the Siskiyous
College of the Siskiyous
@COS_InfoNow
Something went wrong.
Something went wrong.








































































































































